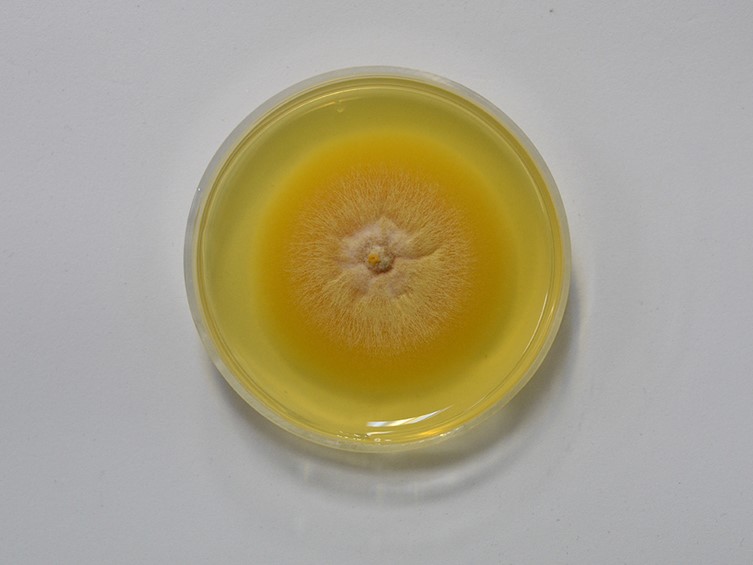

Holotype:
LAOS, Oudomxay Province, Muang Xay County, Nagang Village, 5 October 2019, Yao Wang, holotype: YHH 2301008, ex-type living culture YFCC 1910941.
Habitat:
Underside of a dicotyledonous leaf
Host:
Adult moth (Noctuidae)
Description:
Asexual morph:  Synnemata scattered, arising from different parts of the host’s body, filiform, simple, occasionally branched, white, 3−20 mm long.
Synnemata scattered, arising from different parts of the host’s body, filiform, simple, occasionally branched, white, 3−20 mm long.  Conidiophores densely compacted into a layer along the synnemata, cylindrical, monophialidic or polyphialidic. Phialides smooth-walled, ampulliform, obpyriform, lageniform,
hyaline, 4–10 × 2−3 µm.
Conidiophores densely compacted into a layer along the synnemata, cylindrical, monophialidic or polyphialidic. Phialides smooth-walled, ampulliform, obpyriform, lageniform,
hyaline, 4–10 × 2−3 µm.  Conidia 1-celled, fusiform elliptical, elliptical, smooth-walled, hyaline, 3–6 × 1.5−2 µm. Sexual morph:
Conidia 1-celled, fusiform elliptical, elliptical, smooth-walled, hyaline, 3–6 × 1.5−2 µm. Sexual morph:  Specimens found on adult moths (Lepidoptera), on the underside of dicotyledonous leaves, thin whitish mycelium covering the host body.
Specimens found on adult moths (Lepidoptera), on the underside of dicotyledonous leaves, thin whitish mycelium covering the host body.  Perithecia superficial, clustered along the thin whitish synnemata or solitary, ovoid, light yellow, strong orange, 480–760 × (180–)203−287(–300) µm.
Perithecia superficial, clustered along the thin whitish synnemata or solitary, ovoid, light yellow, strong orange, 480–760 × (180–)203−287(–300) µm.  Asci cylindrical, hyaline, 223–470 × 3−5 µm. Asci-caps umbonate, hyaline, 2.5−3.5 × 3−3.5 µm. Ascospores filiform, multi-septate, breaking into part-spores, hyaline. Part-spores cylindrical, hyaline, 3.5–11.5 × 0.5−1 µm.
Asci cylindrical, hyaline, 223–470 × 3−5 µm. Asci-caps umbonate, hyaline, 2.5−3.5 × 3−3.5 µm. Ascospores filiform, multi-septate, breaking into part-spores, hyaline. Part-spores cylindrical, hyaline, 3.5–11.5 × 0.5−1 µm.
Culture characteristics:
Colony on PDA closely appressed to the agar surface, cottony, entire margin, attaining a diam of 38–42
mm in 20 d, white, produced brilliant greenish yellow pigment.
Colony on PDA closely appressed to the agar surface, cottony, entire margin, attaining a diam of 38–42
mm in 20 d, white, produced brilliant greenish yellow pigment.  Conidiophores on PDA mononematous, cylindrical, smooth-walled, hyaline. Phialides on PDA solitary, cylindrical, smooth-walled, hyaline, 5–32 × 1−1.5 µm.
Conidiophores on PDA mononematous, cylindrical, smooth-walled, hyaline. Phialides on PDA solitary, cylindrical, smooth-walled, hyaline, 5–32 × 1−1.5 µm.  Conidia on PDA 1-celled, obovoid, smooth-walled, hyaline,
2.5–14 × 1−3 µm.
Conidia on PDA 1-celled, obovoid, smooth-walled, hyaline,
2.5–14 × 1−3 µm.
Reference:
A. Khonsanit, D. Thanakitpipattana, S. Mongkolsamrit, et al. (2024). A phylogenetic assessment of Akanthomyces sensu lato in Cordycipitaceae (Hypocreales, Sordariomycetes): introduction of new genera, and the resurrection of Lecanicillium. Fungal Systematics and Evolution14:271–305.
DOI: https://doi.org/10.3114/fuse.2024.14.17Wang Y, Wang ZQ, Luo R, et al. (2024). Species diversity and major host/substrate associations of the genus Akanthomyces (Hypocreales, Cordycipitaceae). MycoKeys_101: 113–141.
Species |
Strain |
Compound |
Pubchem CID |
Biological activity |
Reference |
|---|
|
Strain |
- |
|---|---|
| BCC 49306 | - |
| BCC 52398 | - |
| BCC 74583 | - |